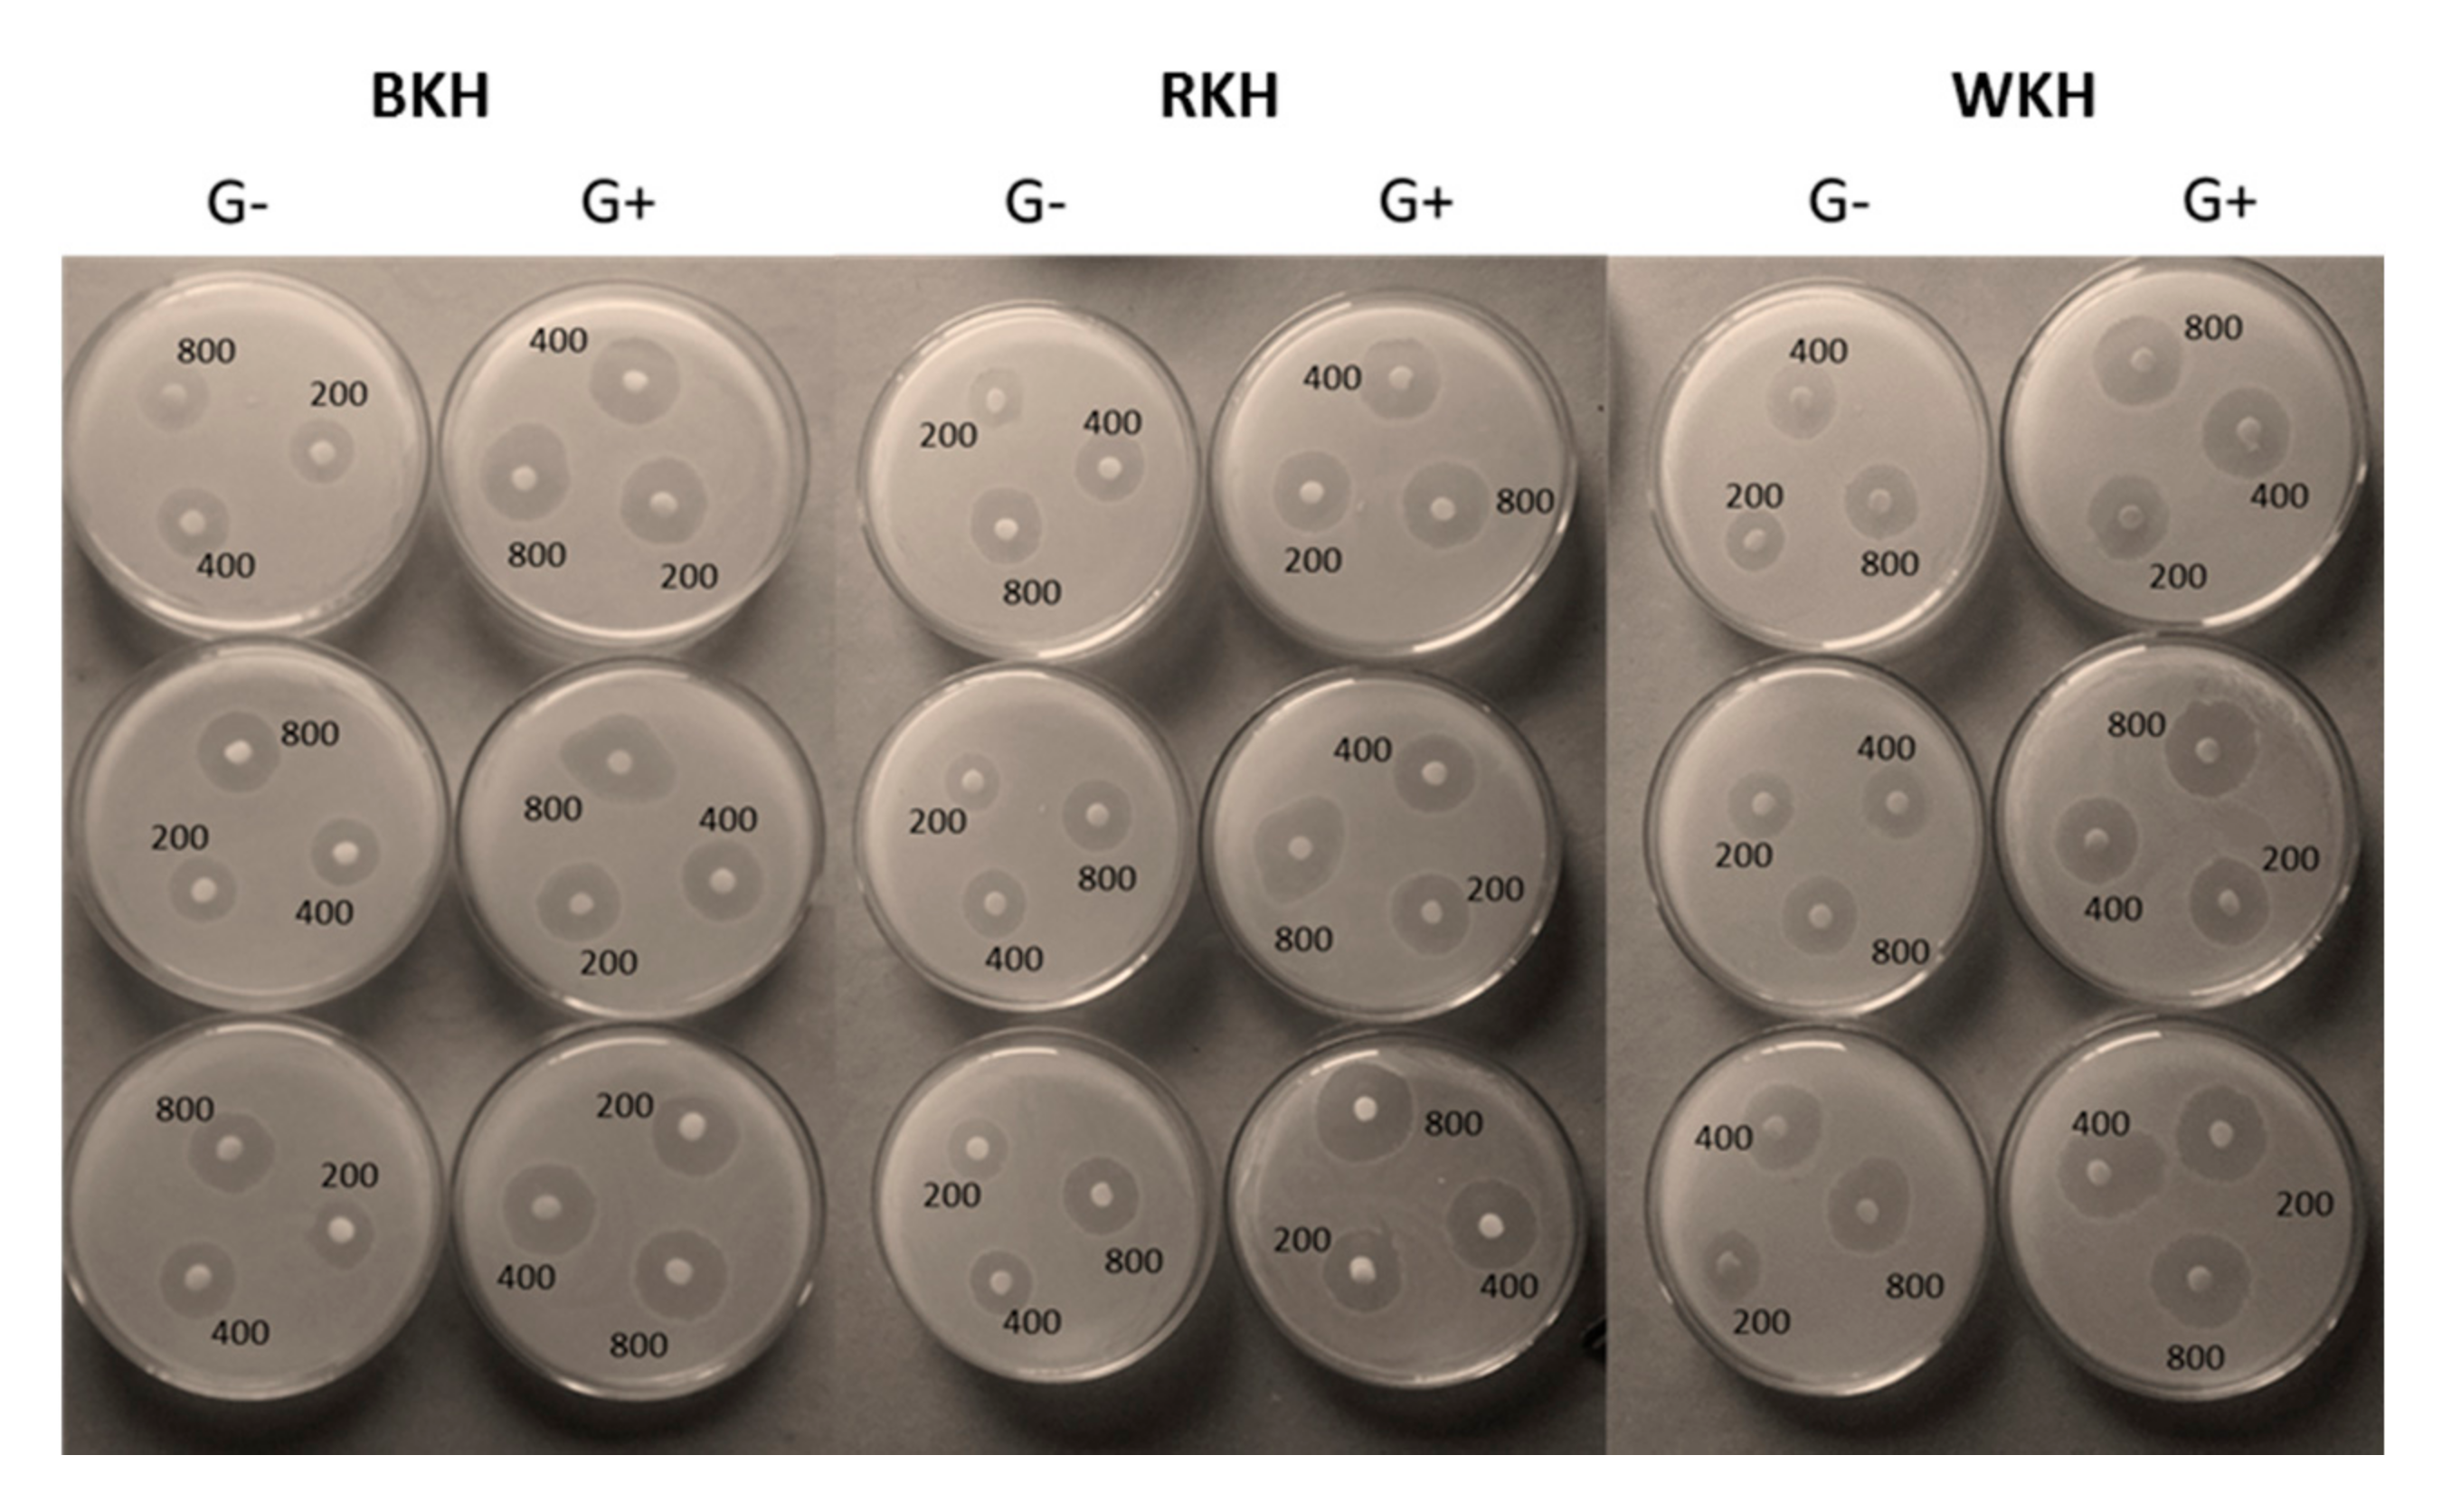

Biochemical and Functional Characterization of Kidney Bean Protein Alcalase-Hydrolysates and Their Preservative Action on Stored Chicken Meat
Abstract
:1. Introduction
2. Materials and Methods
2.1. Protein and Peptides Isolation
2.1.1. Black, Red and White Kidney Bean Protein Isolates (BKI, RKI, and WKI)
2.1.2. Black, Red and White Kidney Bean Alcalase Enzymatic Hydrolysates
2.2. Biochemical Characterization of White, Red, Black Kidney Bean Protein and Hydrolysates
2.2.1. Degree of Hydrolysis (DH)
2.2.2. Sodium Dodecyl Sulfate Polyacrylamide Gel Electrophoresis (SDS-PAGE)
2.2.3. Chemical Analysis of Hydrolysates
2.2.4. Functional Properties of Hydrolysates
Hydrolysates Solubility
Water Absorption Capacity
Oil Absorption Capacity
Foaming Capacity and Foaming Stability
2.2.5. Chemical Constituents of the Hydrolysates
Total Phenolic Compounds (TPC) in The Hydrolysates
Total Flavonoids in the Hydrolysates
Total Anthocyanin Content (TAC) in BKH, RKH, and WKH Peptides
2.2.6. Biological Activity of Hydrolysates
Antioxidant Activity
Antimicrobial Activity
2.3. Preservation of Raw Chicken Meat
2.3.1. Physicochemical Analysis of Meat Sample
pH Estimation
Metmyoglobin (MetMb) Analysis
Lipid Peroxidation Assay
Total Volatile Basic Nitrogen (TVBN)
2.3.2. Sensory Evaluation and Color Measurement
2.3.3. Microbial Analysis
2.4. Statistical Analysis
3. Results and Discussion
3.1. Physico-Chemical Characterization of the Hydrolysates
3.1.1. Chemical Composition of Protein Isolates and Hydrolysates
3.1.2. SDS-PAGE Electrophoretic Pattern
3.1.3. Degree of Hydrolysis (DH)
3.1.4. pH-Protein Solubility
3.1.5. Functional Properties
3.1.6. Total Phenolic, Flavonoids, and Anthocyandins Content
3.1.7. Antioxidant Activity
3.1.8. Antimicrobial Activity of the Hydrolysates
Antibacterial
Antifunga
3.2. Chicken Meat Preservation with Kidney Bean Protein Hydrolysates
3.2.1. Physicochemical Changes during Cold Storage
3.2.2. Fluctuation in Color Parameters and Sensorial Traits of Raw Chicken Meat during 30 Days of Cold Storage
3.2.3. Microbial Changes in Chicken Meat during 30 Days Cold Storage
4. Conclusions
Author Contributions
Funding
Institutional Review Board Statement
Informed Consent Statement
Data Availability Statement
Conflicts of Interest
Sample Availability
References
- Fratamico, P.M.; Bhunia, A.K.; Smith, J.L. Foodborne Pathogens: Microbiology and Molecular Biology; CRC Press LLC: Boca Raton, FL, USA, 2005. [Google Scholar]
- CDC. Available online: https://www.cdc.gov/foodsafety/foodborne-germs.html (accessed on 27 July 2021).
- Anyasi, T.; Jideani, A.I.; Mchau, G.R. Effects of organic acid pretreatment on microstructure, functional and thermal properties of unripe banana flour. J. Food Meas. Charact. 2016, 11, 99–110. [Google Scholar] [CrossRef] [Green Version]
- Seabra, R.M.; Andrade, P.B.; Valentao, P.; Fernandes, E.; Carvalho, F.; Bastos, M. Anti-oxidant compounds extracted from several plant materials. In Biomaterials from Aquatic and Terrestrial Organisms; CRC Press: Raton, FL, USA, 2006; pp. 115–174. [Google Scholar]
- El-Hack, M.E.A.; El-Saadony, M.T.; Shafi, M.E.; Zabermawi, N.M.; Arif, M.; Batiha, G.E.; Khafaga, A.F.; El-Hakim, Y.M.A.; Al-Sagheer, A.A. Antimicrobial and antioxidant properties of chitosan and its derivatives and their applications: A review. Int. J. Biol. Macromol. 2020, 164, 2726–2744. [Google Scholar] [CrossRef]
- Abdelnour, S.A.; Swelum, A.A.; Salama, A.; Al-Ghadi, M.Q.; Qattan, S.Y.A.; El-Hack, M.E.A.; Khafaga, A.F.; Alhimaidi, A.R.; Almutairi, B.O.; Ammari, A.A.; et al. The beneficial impacts of dietary phycocyanin supplementation on growing rabbits under high ambient temperature. Ital. J. Anim. Sci. 2020, 19, 1046–1056. [Google Scholar] [CrossRef]
- Ashour, E.; El-Hack, M.; Shafi, M.; Alghamdi, W.; Taha, A.; Swelum, A.; Tufarelli, V.; Mulla, Z.; El-Ghareeb, W.; El-Saadony, M. Impacts of Green Coffee Powder Supplementation on Growth Performance, Carcass Characteristics, Blood Indices, Meat Quality and Gut Microbial Load in Broilers. Agriculture 2020, 10, 457. [Google Scholar] [CrossRef]
- El-Saadony, M.T.; Sitohy, M.Z.; Ramadan, M.F.; Saad, A.M. Green nanotechnology for preserving and enriching yogurt with bio-logically available iron (II). Innov. Food Sci. Emerg. Technol. 2021, 69, 102645. [Google Scholar] [CrossRef]
- Osman, A.O.; Mahgoub, S.A.; Sitohy, M.Z. Preservative action of 11S (glycinin) and 7S (β-conglycinin) soy globulin on bovine raw milk stored either at 4 or 25 °C. J. Dairy Res. 2013, 80, 174–183. [Google Scholar] [CrossRef] [PubMed]
- Sitohy, M.Z.; Osman, A.O. Enhancing Milk Preservation with Esterified Legume Proteins. Probiotics Antimicrob. Proteins 2011, 3, 48–56. [Google Scholar] [CrossRef] [PubMed]
- Sitohy, M.; Mahgoub, S.; Osman, A. Controlling psychrotrophic bacteria in raw buffalo milk preserved at 4oC with esterified legume proteins. LWT- Food Sci. Technol. 2011, 44, 1697–1702. [Google Scholar] [CrossRef]
- Mahgoub, S.; Osman, A.; Sitohy, M. Inhibition of Growth of Pathogenic Bacteria in Raw Milk by Legume Protein Esters. J. Food Prot. 2011, 74, 1475–1481. [Google Scholar] [CrossRef]
- Mahgoub, S.A.; Sitohy, M.Z.; Osman, A.O. Counteracting Recontamination of Pasteurized Milk by Methylated Soybean Protein. Food Bioprocess. Technol. 2011, 6, 101–109. [Google Scholar] [CrossRef]
- Osman, A.; Mahgoub, S.; El-Masry, R.; Al-Gaby, A.; Sitohy, M. Extending the Technological Validity of Raw Buffalo Milk at Room Temperature by Esterified Legume Proteins. J. Food Process. Preserv. 2012, 38, 223–231. [Google Scholar] [CrossRef]
- El-Saadony, M.T.; Khalil, O.S.F.; Osman, A.; Alshilawi, M.S.; Taha, A.E.; Aboelenin, S.M.; Shukry, M.; Saad, A.M. Bioactive peptides supplemented raw buffalo milk: Biological activity, shelf life and quality properties during cold preservation. Saudi, J. Biol. Sci. 2021. [Google Scholar] [CrossRef]
- Osman, A.; Goda, H.A.; Sitohy, M. Storage stability of minced beef supplemented with chickpea legumin at 4 C as a potential sub-stitute for nisin. LWT- Food Sci. Technol. 2018, 93, 434–441. [Google Scholar] [CrossRef]
- Osman, A.; Abdel-Shafi, S.; Al-Mohammadi, A.-R.; Kamal, N.; Enan, G.; Sitohy, M. Catfish glycoprotein, a highly powerful safe preservative of minced beef stored at 4 C for 15 Days. Foods 2020, 9, 1115. [Google Scholar] [CrossRef]
- El-Saadony, M.T.; El-Hack, M.E.A.; Swelum, A.A.; Al-Sultan, S.I.; El-Ghareeb, W.R.; Hussein, E.O.S.; Ba-Awadh, H.A.; Akl, B.A.; Nader, M.M. Enhancing quality and safety of raw buffalo meat using the bioactive peptides of pea and red kidney bean under refrigeration conditions. Ital. J. Anim. Sci. 2021, 20, 762–776. [Google Scholar] [CrossRef]
- Abdel-Hamid, M.; Osman, A.; El-Hadary, A.; Romeih, E.; Sitohy, M.; Li, L. Hepatoprotective action of papain-hydrolyzed buffalo milk protein on carbon tetrachloride oxidative stressed albino rats. J. Dairy Sci. 2020, 103, 1884–1893. [Google Scholar] [CrossRef] [PubMed]
- Al-Mohammadi, A.-R.; Osman, A.; Enan, G.; Abdel-Shafi, S.; El-Nemer, M.; Sitohy, M.; Taha, M. Powerful Antibacterial Peptides from Egg Albumin Hydrolysates. Antibiotics 2020, 9, 901. [Google Scholar] [CrossRef] [PubMed]
- Saad, A.M.; Osman, A.O.M.; Mohamed, A.S.; Ramadan, M.F. Enzymatic hydrolysis of Phaseolus vulgaris protein isolate: Charac-terization of hydrolysates and effect on the quality of minced beef during cold storage. Int. J. Pept. Res. Ther. 2020, 26, 567–577. [Google Scholar] [CrossRef]
- Liu, D.; Chen, X.; Huang, J.; Huang, M.; Zhou, G. Generation of bioactive peptides from duck meat during post-mortem aging. Food Chem. 2017, 237, 408–415. [Google Scholar] [CrossRef] [PubMed]
- Lafarga, T.; Hayes, M. Bioactive peptides from meat muscle and by-products: Generation, functionality and application as functional ingredients. Meat Sci. 2014, 98, 227–239. [Google Scholar] [CrossRef]
- Escudero, E.; Mora, L.; Fraser, P.D.; Aristoy, M.-C.; Toldrá, F. Identification of novel antioxidant peptides generated in Spanish dry-cured ham. Food Chem. 2013, 138, 1282–1288. [Google Scholar] [CrossRef]
- Stadnik, J.; Kęska, P. Meat and fermented meat products as a source of bioactive peptides. Acta Sci. Pol. Technol. Aliment. 2015, 14, 181–190. [Google Scholar] [CrossRef] [PubMed]
- Udenigwe, C.C.; Aluko, R.E. Chemometric Analysis of the Amino Acid Requirements of Antioxidant Food Protein Hydrolysates. Int. J. Mol. Sci. 2011, 12, 3148–3161. [Google Scholar] [CrossRef] [PubMed] [Green Version]
- Faustino, A.M.; Veiga, M.; Sousa, P.; Costa, E.M.; Silva, S.; Pintado, M. Agro-Food Byproducts as a New Source of Natural Food Additives. Molecules 2019, 24, 1056. [Google Scholar] [CrossRef] [PubMed] [Green Version]
- El-Saadony, M.T.; Saad, A.M.; Najjar, A.A.; Alzahrani, S.O.; Alkhatib, F.M.; Shafi, M.E.; Selem, E.; Desoky, E.-S.M.; Fouda, S.E.E.; El-Tahan, A.M. The use of biological selenium nanoparticles in controlling Triticum aestivum L. crown root and rot diseases induced by Fusarium species and improve yield under drought and heat stress. Saudi J. Biol. Sci. 2021, 28, 4461–4471. [Google Scholar]
- El-Saadony, M.T.; Desoky, E.-S.M.; Saad, A.M.; Eid, R.S.; Selem, E.; Elrys, A.S. Biological silicon nanoparticles improve Phaseolus vulgaris L. yield and minimize its contaminant contents on a heavy metals-contaminated saline soil. J. Environ. Sci. 2021, 106, 1–14. [Google Scholar] [CrossRef]
- Dueñas, M.; Martínez-Villaluenga, C.; Limón, R.I.; Peñas, E.; Frias, J. Effect of germination and elicitation on phenolic composition and bioactivity of kidney beans. Food Res. Int. 2015, 70, 55–63. [Google Scholar] [CrossRef] [Green Version]
- Romero, J.; Sun, S.-M.M.; McLeester, R.C.; Bliss, F.A.; Hall, T.C. Heritable Variation in a Polypeptide Subunit of the Major Storage Protein of the Bean, Phaseolus vulgaris L. Plant. Physiol. 1975, 56, 776–779. [Google Scholar] [CrossRef] [Green Version]
- Los, F.G.B.; Demiate, I.M.; Dornelles, R.C.P.; Lamsal, B. Enzymatic hydrolysis of Carioca bean (Phaseolus vulgaris L.) protein as an alternative to commercially rejected grains. LWT 2020, 125, 109191. [Google Scholar] [CrossRef]
- Mamboya, E.A.F. Papain, a plant enzyme of biological importance: A review. Am. J. Biochem. Biotechnol. 2012, 8, 99–104. [Google Scholar]
- Sarmadi, B.H.; Ismail, A. Antioxidative peptides from food proteins: A review. Peptides 2010, 31, 1949–1956. [Google Scholar] [CrossRef]
- Noman, A.; Xu, Y.; Al-Bukhaiti, W.Q.; Abed, S.M.; Ali, A.; Ramadhan, A.H.; Xia, W. Influence of enzymatic hydrolysis conditions on the degree of hydrolysis and functional properties of protein hydrolysate obtained from Chinese sturgeon (Acipenser sinensis) by using papain enzyme. Process. Biochem. 2018, 67, 19–28. [Google Scholar] [CrossRef]
- Bumrungsart, N.; Duangmal, K. Optimization of Enzymatic Hydrolysis Condition for Producing Black Gram Bean (Vigna mungo) Hydrolysate with High Antioxidant Activity. Food Appl. Biosci. J. 2019, 7, 105–117. [Google Scholar]
- Meshginfar, N.; Mahoonak, A.S.; Ghorbani, M.; Aalami, M. Effects of Protein Hydrolysate from Sheep Visceral on Oxidative Stability of Soybean Oil and Chicken Sausage. J. Food Process. Preserv. 2016, 41, e12875. [Google Scholar] [CrossRef]
- El-Saadony, M.T.; Elsadek, M.F.; Mohamed, A.S.; Taha, A.E.; Ahmed, B.M.; Saad, A.M. Effects of chemical and natural additives on cucumber juice’s quality, shelf life, and safety. Foods 2020, 9, 639. [Google Scholar] [CrossRef]
- Saad, A.M.; Mohamed, A.S.; El-Saadony, M.T.; Sitohy, M.Z. Palatable functional Cucumber juices supplemented with polyphe-nols-rich herbal extracts. LWT- Food Sci. Technol. 2021, 148, 111668. [Google Scholar] [CrossRef]
- Johnson, E.A.; Brekke, C.J. Functional Properties of Acylated Pea Protein Isolates. J. Food Sci. 1983, 48, 722–725. [Google Scholar] [CrossRef]
- Holye, N.T.; Merrltt, J.H. Quality of fish protein hydrolysates from herring (Clupea harengus). J. Food Sci. 1994, 59, 76–79. [Google Scholar] [CrossRef]
- Laemmli, U.K. Cleavage of Structural Proteins during the Assembly of the Head of Bacteriophage T4. Nature 1970, 227, 680–685. [Google Scholar] [CrossRef]
- Roy, M.; Sarker, A.; Azad, A.K.; Shaheb, R.; Hoque, M. Evaluation of antioxidant and antimicrobial properties of dark red kidney bean (Phaseolus vulgaris) protein hydrolysates. J. Food Meas. Charact. 2019, 14, 303–313. [Google Scholar] [CrossRef]
- Chobert, J.-M.; Touati, A.; Bertrand-Harb, C.; Dalgalarrondo, M.; Nicolas, M.-G.; Haertle, T. In vitro proteolysis and functional properties of reductively alkylated β-casein derivatives. J. Dairy Res. 1991, 58, 285–298. [Google Scholar] [CrossRef]
- AOAC. Official Methods of Analysis, 18th ed.; Pub AOAC International Maryland: Rockville, MD, USA, 2005. [Google Scholar]
- Wani, I.A.; Sogi, D.; Gill, B.S. Physicochemical and functional properties of flours from three Black gram (Phaseolus mungo L.) cultivars. Int. J. Food Sci. Technol. 2012, 48, 771–777. [Google Scholar] [CrossRef]
- Wani, I.A.; Sogi, D.S.; Gill, B.S. Physico-chemical and functional properties of native and hydrolysed protein isolates from Indian black gram (Phaseolus mungo L.) cultivars. LWT 2015, 60, 848–854. [Google Scholar] [CrossRef]
- Škerget, M.; Kotnik, P.; Hadolin, M.; Hraš, A.R.; Simonič, M.; Knez, Ž. Phenols, proanthocyanidins, flavones and flavonols in some plant materials and their antioxidant activities. Food Chem. 2005, 89, 191–198. [Google Scholar] [CrossRef]
- Ordonez, A.; Gomez, J.; Vattuone, M.; Lsla, M. Antioxidant activities of Sechium edule (Jacq.) Swartz extracts. Food Chem. 2006, 97, 452–458. [Google Scholar] [CrossRef]
- Giusti, M.; Wrolstad, R.E. Characterization and Measurement of Anthocyanins by UV-Visible Spectroscopy. Curr. Protoc. Food Anal. Chem. 2001. [Google Scholar] [CrossRef]
- Hatano, T.; Kagawa, H.; Yasuhara, T.; Okuda, T. Two new flavonoids and other constituents in licorice root. Their relative astringency and radical scavenging effects. Chem. Pharm. Bull. 1988, 36, 2090–2097. [Google Scholar] [CrossRef] [Green Version]
- Dastmalchi, K.; Dorman, H.D.; Laakso, I.; Hiltunen, R. Chemical composition and antioxidative activity of Moldavian balm (Dra-cocephalum moldavica L.) extracts. LWT- Food Sci. Technol. 2007, 40, 1655–1663. [Google Scholar] [CrossRef]
- El-Saadony, M.T.; Alkhatib, F.M.; Alzahrani, S.O.; Shafi, M.E.; Abdel-Hamid, S.E.; Taha, T.F.; Aboelenin, S.M.; Soliman, M.M.; Ahmed, N.H. Impact of mycogenic zinc nanoparticles on performance, behavior, immune response, and microbial load in Oreochromis niloticus. Saudi J. Biol. Sci. 2021, 28, 4592–4604. [Google Scholar] [CrossRef]
- El-Saadony, M.T.; El-Wafai, N.A.; El-Fattah, H.I.A.; Mahgoub, S. Biosynthesis, Optimization and Characterization of Silver Nanoparticles Using a Soil Isolate of Bacillus pseudomycoides MT32 and their Antifungal Activity Against some Pathogenic Fungi. Adv. Anim. Vet. Sci. 2019, 7, 238–249. [Google Scholar] [CrossRef] [Green Version]
- Alizadeh, H.; Rahnema, M.; Semnani, S.N.; Ajalli, M. Synergistic antifungal effects of quince leaf’s extracts and silver nanoparticles on Aspergillus niger. J. Appl. Biol. Sci. 2014, 8, 10–13. [Google Scholar]
- Özyurt, G.; Kuley, E.; Balikçi, E.; Kaçar, Ç; Gökdogan, S.; Etyemez, M.; Ozogul, F. Effect of the Icing with Rosemary Extract on the Oxidative Stability and Biogenic Amine Formation in Sardine (Sardinella aurita) During Chilled Storage. Food Bioprocess. Technol. 2011, 5, 2777–2786. [Google Scholar] [CrossRef]
- Badr, H.M. Antioxidative activity of carnosine in gamma irradiated ground beef and beef patties. Food Chem. 2007, 104, 665–679. [Google Scholar] [CrossRef]
- Krzywicki, K. The determination of haem pigments in meat. Meat Sci. 1982, 7, 29–36. [Google Scholar] [CrossRef]
- Niehaus Jr, W.; Samuelsson, B. Formation of malonaldehyde from phospholipid arachidonate during microsomal lipid peroxidation. Eur. J. Biochem. 1968, 6, 126–130. [Google Scholar] [CrossRef] [PubMed]
- Idakwo, P.Y.; Negbenebor, C.A.; Badau, M.H.; Gbenyi, D.I. Total volatile base nitrogen (TVBN) and trimethylamine (TMA) content of “Bunyi youri” as influenced by the addition of glucose and clove during storage. Int. J. Biotechnol. Food Sci. 2016, 4, 81–85. [Google Scholar]
- Piga, A.; Catzeddu, P.; Farris, S.; Roggio, T.; Sanguinetti, A.; Scano, E. Texture evolution of “Amaretti” cookies during storage. Eur. Food Res. Technol. 2005, 221, 387–391. [Google Scholar] [CrossRef] [Green Version]
- Hunter, R. Scales for the Measurements of Color Difference. The Measurement of Appearance; John Willy & Sons: New York, NY, USA, 1975; pp. 133–140. [Google Scholar]
- Saad, A.M.; El-Saadony, M.T.; Mohamed, A.S.; Ahmed, A.I.; Sitohy, M.Z. Impact of cucumber pomace fortification on the nutri-tional, sensorial and technological quality of soft wheat flour-based noodles. Int. J. Food Sci. Technol. 2021, 56, 3255–3268. [Google Scholar] [CrossRef]
- Abdelnour, S.; El-Saadony, M.; Saghir, S.; El-Hack, M.A.; Al-Shargi, O.; Al-Gabri, N.; Salama, A. Mitigating negative impacts of heat stress in growing rabbits via dietary prodigiosin supplementation. Livest. Sci. 2020, 240, 104220. [Google Scholar] [CrossRef]
- Reda, F.M.; El-Saadony, M.T.; ElNesr, S.S.; Alagawany, M.; Tufarelli, V. Effect of Dietary Supplementation of Biological Curcumin Nanoparticles on Growth and Carcass Traits, Antioxidant Status, Immunity and Caecal Microbiota of Japanese Quails. Animals 2020, 10, 754. [Google Scholar] [CrossRef]
- Reda, F.M.; El-Saadony, M.T.; El-Rayes, T.K.; Attia, A.I.; El-Sayed, S.A.; Ahmed, S.Y.; Madkour, M.; Alagawany, M. Use of biological nano zinc as a feed additive in quail nutrition: Biosynthesis, antimicrobial activity and its effect on growth, feed utilisation, blood metabolites and intestinal microbiota. Ital. J. Anim. Sci. 2021, 20, 324–335. [Google Scholar] [CrossRef]
- Sheiha, A.M.; Abdelnour, S.A.; El-Hack, A.; Mohamed, E.; Khafaga, A.F.; Metwally, K.A.; Ajarem, J.S.; Maodaa, S.N.; Allam, A.A.; El-Saadony, M.T. Effects of dietary biological or chemical-synthesized nano-selenium supplementation on growing rabbits ex-posed to thermal stress. Animals 2020, 10, 430. [Google Scholar] [CrossRef] [Green Version]
- Evangelho, J.A.d.; Berrios, J.d.J.; Pinto, V.Z.; Antunes, M.D.; Vanier, N.L.; Zavareze, E.d.R. Antioxidant activity of black bean (Phaseolus vulgaris L.) protein hydrolysates. Food Sci. Technol. 2016, 36, 23–27. [Google Scholar] [CrossRef] [Green Version]
- del Mar Yust, M.; Pedroche, J.; del Carmen Millán-Linares, M.; Alcaide-Hidalgo, J.M.; Millán, F. Improvement of functional prop-erties of chickpea proteins by hydrolysis with immobilised Alcalase. Food Chem. 2010, 122, 1212–1217. [Google Scholar] [CrossRef]
- Evangelho, J.A.D.; Vanier, N.; Pinto, V.Z.; De Berrios, J.J.; Dias, A.R.G.; Zavareze, E.D.R. Black bean (Phaseolus vulgaris L.) protein hydrolysates: Physicochemical and functional properties. Food Chem. 2017, 214, 460–467. [Google Scholar] [CrossRef]
- de Toledo, N.M.V.; Rocha, L.C.; da Silva, A.G.; Brazaca, S.G.C. Interaction and digestibility of phaseolin/polyphenol in the common bean. Food Chem. 2013, 138, 776–780. [Google Scholar] [CrossRef] [Green Version]
- Abdel-Hamid, M.; Otte, J.; De Gobba, C.; Osman, A.; Hamad, E. Angiotensin I-converting enzyme inhibitory activity and antioxi-dant capacity of bioactive peptides derived from enzymatic hydrolysis of buffalo milk proteins. Int. Dairy J. 2017, 66, 91–98. [Google Scholar] [CrossRef]
- Moure, A.; Sineiro, J.; Domínguez, H.; Parajó, J.C. Functionality of oilseed protein products: A review. Food Res. Int. 2006, 39, 945–963. [Google Scholar] [CrossRef]
- Osman, A.; El-Didamony, G.; Sitohy, M.; Khalifa, M.; Enan, G. Soybean glycinin basic subunit inhibits methicillin re-sistant-vancomycin intermediate Staphylococcus aureus (MRSA-VISA) in vitro. Int. J. Appl. Res. Nat. Prod. 2016, 9, 17–26. [Google Scholar]
- Wahdan, K.; Saad, A. Antibacterial and Antioxidant Activities of an Enzymatic Hydrolysate Kidney Bean (Phaseolus vulgaris L.) Protein Isolates. J. Agric. Chem. Biotechnol. 2018, 9, 85–89. [Google Scholar] [CrossRef]
- Eckert, E.; Han, J.; Swallow, K.; Tian, Z.; Jarpa-Parra, M.; Chen, L. Effects of enzymatic hydrolysis and ultrafiltration on physico-chemical and functional properties of faba bean protein. Cereal Chem. 2019, 96, 725–741. [Google Scholar] [CrossRef]
- Sarker, A.; Chakraborty, S.; Roy, M. Dark red kidney bean (Phaseolus vulgaris L.) protein hydrolysates inhibit the growth of oxidizing substances in plain yogurt. J. Agric. Food Res. 2020, 2, 100062. [Google Scholar] [CrossRef]
- Jakobek, L. Interactions of polyphenols with carbohydrates, lipids and proteins. Food Chem. 2015, 175, 556–567. [Google Scholar] [CrossRef]
- Torre, P.; Aliakbarian, B.; Rivas, B.; Domínguez, J.M.; Converti, A. Release of ferulic acid from corn cobs by alkaline hydrolysis. Biochem. Eng. J. 2008, 40, 500–506. [Google Scholar] [CrossRef]
- Vijitpunyaruk, T.; Theerakulkait, C. Preparation of alcalase hydrolysed rice bran protein concentrate and its inhibitory effect on soybean lipoxygenase activity. Int. J. Food Sci. Technol. 2013, 49, 501–507. [Google Scholar] [CrossRef]
- Esfandi, R.; Walters, M.E.; Tsopmo, A. Antioxidant properties and potential mechanisms of hydrolyzed proteins and peptides from cereals. Heliyon 2019, 5, e01538. [Google Scholar] [CrossRef] [PubMed] [Green Version]
- Nwachukwu, I.D.; Aluko, R.E. Structural and functional properties of food protein-derived antioxidant peptides. J. Food Biochem. 2019, 43, e12761. [Google Scholar] [CrossRef] [PubMed] [Green Version]
- Breijyeh, Z.; Jubeh, B.; Karaman, R. Resistance of Gram-Negative Bacteria to Current Antibacterial Agents and Approaches to Resolve It. Molecules 2020, 25, 1340. [Google Scholar] [CrossRef] [Green Version]
- Benkerroum, N. Antimicrobial peptides generated from milk proteins: A survey and prospects for application in the food industry. A review. Int. J. Dairy Technol. 2010, 63, 320–338. [Google Scholar] [CrossRef]
- Lei, J.; Sun, L.; Huang, S.; Zhu, C.; Li, P.; He, J.; Mackey, V.; Coy, D.H.; He, Q. The antimicrobial peptides and their potential clinical applications. Am. J. Transl. Res. 2019, 11, 3919–3931. [Google Scholar]
- Karabagias, I.; Badeka, A.; Kontominas, M. Shelf life extension of lamb meat using thyme or oregano essential oils and modified atmosphere packaging. Meat Sci. 2011, 88, 109–116. [Google Scholar] [CrossRef] [PubMed]
- Chaijan, M. Lipid and myoglobin oxidations in muscle foods. Songklanakarin J. Sci. Technol. 2008, 30, 47–53. [Google Scholar]
- Citta, A.; Folda, A.; Scalcon, V.; Scutari, G.; Bindoli, A.; Bellamio, M.; Feller, E.; Rigobello, M.P. Oxidative changes in lipids, proteins, and antioxidants in yogurt during the shelf life. Food Sci. Nutr. 2017, 5, 1079–1087. [Google Scholar] [CrossRef]
- Piñuel, M.L.; Vilcacundo, E.; Boeri, P.A.; Barrio, D.A.; Morales, D.; Pinto, A.; Moran, R.; Samaniego, I.; Carrillo, W. Extraction of protein concentrate from red bean (Phaseolus vulgaris L.): Antioxidant activity and inhibition of lipid peroxidation. J. Appl. Pharm. Sci. 2019, 9, 1–14. [Google Scholar]
- Aslam, S.; Shukat, R.; Khan, M.I.; Shahid, M. Effect of Dietary Supplementation of Bioactive Peptides on Antioxidant Potential of Broiler Breast Meat and Physicochemical Characteristics of Nuggets. Food Sci. Anim. Resour. 2020, 40, 55–73. [Google Scholar] [CrossRef] [Green Version]
- Ab Aziz, M.F.; Hayat, M.N.; Kaka, U.; Kamarulzaman, N.H.; Sazili, A.Q. Physico-Chemical Characteristics and Microbiological Quality of Broiler Chicken Pectoralis Major Muscle Subjected to Different Storage Temperature and Duration. Foods 2020, 9, 741. [Google Scholar] [CrossRef]
- Manigiri, G.; Prajapati, B.; Solanki, B.; Shishir, N.; Shendurse, A. Shelf Life Evaluation of Chicken Meat Nuggets Incorporated with Gooseberry (Pulp and Seed Coat) Powder as Natural Preservatives at Refrigerated Storage (4 ± 1°C). Int. J. Livest. Res. 2019, 9, 53–63. [Google Scholar] [CrossRef]
- Egyptian Standard, S.E. Fresh Meat; Egyptian Organization for Standardization and Quality Control: Cairo, Egypt, 2004; (No.4334/2004).

| Chemical Composition (%) | Black Kidney Bean | Red Kidney Bean | White Kidney Bean | ||||||
|---|---|---|---|---|---|---|---|---|---|
| Material Status | T | I | H | T | I | H | T | I | H |
| Protein | 24.5 ± 0.1 c | 91 ± 1.1 a | 88 ± 0.7 ab | 22.7 ± 0.7 cd | 88.9 ± 1.2 ab | 85 ± 1 b | 21.3 ± 0.6 d | 85 ± 0.9 b | 82 ± 0.6 bc |
| Carbohydrates | 62.1 ± 0.3 ab | 32.5 ± 0.4 c | 4.7 ± 0.1 e | 65.1 ± 0.8 a | 36.7 ± 0.8 b | 8.7 ± 0.2 d | 64.2 ± 0.8 a | 37.2 ± 0.5 b | 8.3 ± 0.1 d |
| Fat | 2.1 ± 0.1 b | ND | ND | 2.5 ± 0.1 ab | ND | ND | 3.1 ± 0.1 a | ND | ND |
| Ash | 4.5 ± 0.3 d | 6.4 ± 0.1 b | 7.3 ± 0.2 ab | 4.19 ± 0.2 d | 5.7 ± 0.1 c | 6.5 ± 0.1 b | 5.1 ± 0.2 cd | 7.2 ± 0.2 ab | 9.4 ± 0.1 a |
| Moisture | 5.8 ± 0.1 b | 3.1 ± 0.1 cd | ND | 6.14 ± 0.2 ab | 3.5 ± 0.1 c | 0.88 ± 0.03 e | 6.45 ± 0.1 a | 1.5 ± 0.01 d | 0.98 ± 0.02 e |
| Protein Hydrolysate | Functional Properties | |||||
|---|---|---|---|---|---|---|
| HT (min) | WAC (g/g) | OAC (g/g) | FS (min) | |||
| pH 3 | pH 5 | pH 7 | ||||
| BKH | 0 | 6.9 ± 0.5 d | 6.8 ± 0.2 d | 23 ± 0.1 c | 65 ± 0.3 c | 26 ± 0.6 c |
| 30 | 9.4 ± 0.2 a | 10.5 ± 0.6 a | 27 ± 0.3 a | 88 ± 0.9 a | 30 ± 0.8 a | |
| RKH | 0 | 6.7 ± 0.4 de | 6.5 ± 0.3 de | 20 ± 0.8 d | 44 ± 0.8 e | 23 ± 0.2 d |
| 30 | 8.2 ± 0.8 b | 9.3 ± 0.1 b | 25 ± 0.6 b | 75 ± 0.7 b | 28 ± 0.5 b | |
| WKH | 0 | 6.1 ± 0.3 e | 6.0 ± 0.1 e | 18 ± 0.9 e | 29 ± 0.1 f | 21 ± 0.4 e |
| 30 | 7.2 ± 0.1 c | 8.1 ± 0.2 c | 22 ± 0.7 cd | 50 ± 0.9 d | 25 ± 0.3 cd | |
| Concn (µg/mL) | Total Phenolic (mg GAE/g) | Total Flavonoids (mg QE/g) | Total Anthocyanin (µg/mL) | ||||||
|---|---|---|---|---|---|---|---|---|---|
| BKH | RKH | WKH | BKH | RKH | WKH | BKH | RKH | WKH | |
| 50 | 11.2 ± 0.1 e | 9.5 ± 0.5 e | 7.2 ± 0.9 e | 6.5 ± 0.1 e | 5.2 ± 0.1 e | 6.2 ± 0.3 d | 1.90 ± 0.1 d | 1.02 ± 0.01 e | 0.11 ± 0.02 d |
| 100 | 17.4 ± 0.5 d | 15.4 ± 0.4 d | 12.4 ± 0.8 d | 8.7 ± 0.2 d | 7.1 ± 0.3 d | 8.1 ± 0.2 c | 2.56 ± 0.2 c | 1.56 ± 0.09 d | 0.25 ± 0.01 c |
| 200 | 31.6 ± 0.7 c | 28.7 ± 0.3 c | 24.3 ± 0.6 c | 11.9 ± 0.1 c | 10 ± 0.2 c | 12.2 ± 0.4 b | 4.5 ± 0.2 bc | 2.45 ± 0.1 c | 0.30 ± 0.01 bc |
| 400 | 39.6 ± 1.1 b | 35.5 ± 0.2 b | 33.8 ± 0.7 b | 14.1 ± 0.4 b | 12.5 ± 0.5 b | 13.2 ± 0.7 ab | 4.77 ± 0.3 b | 2.89 ± 0.1 b | 0.34 ± 0.03 b |
| 800 | 63.3 ± 1.5 a | 60.6 ± 0.9 a | 55.8 ± 1.2 a | 16.2 ± 0.8 a | 15.8 ± 0.3 a | 14.4 ± 0.6 a | 5.6 ± 0.4 a | 3.12 ± 0.2 a | 0.8 ± 0.04 a |
| Bacteria | BKH | RKH | WKH | ||||||||||||
|---|---|---|---|---|---|---|---|---|---|---|---|---|---|---|---|
| 50 | 100 | 200 | 400 | 800 | 50 | 100 | 200 | 400 | 800 | 50 | 100 | 200 | 400 | 800 | |
| G+ | |||||||||||||||
| B. cereus | 15 ± 0.0 ab | 21 ± 0.14 b | 23 ± 0.21 b | 26 ± 0.16 b | 28 ± 0.11 b | 14 ± 0.11 ab | 19 ± 0.15 b | 22 ± 0.14 b | 24 ± 0.12 b | 27 ± 0.21 b | - | 15 ± 0.25 b | 21 ± 0.21 ab | 23 ± 0.12 b | 27 ± 0.33 b |
| L. monocytogenes | 14 ± 0.11 b | 19 ± 0.22 c | 21 ± 0.14 c | 25 ± 0.14 bc | 27 ± 0.17 bc | 13 ± 0.34 b | 18 ± 0.19 bc | 21 ± 0.15 bc | 23 ± 0.18 bc | 26 ± 0.28 bc | - | 13 ± 0.14 c | 19 ± 0.15 b | 22 ± 0.14 bc | 26 ± 0.14 bc |
| S. pyogenes | 16 ± 0.14 a | 23 ± 0.21 a | 26 ± 0.19 a | 29 ± 0.15 a | 33 ± 0.0 a | 15 ± 0.22 a | 22 ± 0.23 a | 24 ± 0.19 a | 27 ± 0.23 a | 31 ± 0.19 a | - | 17 ± 0.16 a | 22 ± 0.17 a | 25 ± 0.18 a | 30 ± 0.25 a |
| G- | |||||||||||||||
| E. coli | 13 ± 0.18 bc | 18 ± 0.15 cd | 20 ± 0.0 cd | 23 ± 0.22 c | 25 ± 0.23 c | - | 16 ± 0.14 c | 19 ± 0.22 c | 21 ± 0.17 c | 24 ± 0.17 c | - | 12 ± 0.18 cd | 18 ± 0.19 bc | 21 ± 0.19 c | 25 ± 0.41 c |
| C. jejuni | 10 ± 0.21 d | 14 ± 0.12 e | 16 ± 0.21 e | 20 ± 0.23 e | 22 ± 0.12 e | - | 12 ± 0.51 e | 15 ± 0.31 e | 18 ± 0.55 e | 20 ± 0.15 e | - | 10 ± 0.32 e | 13 ± 0.23 d | 18 ± 0.21 d | 21 ± 0.23 e |
| S. typhi | 11 ± 0.13 c | 16 ± 0.21 d | 19 ± 0.32 d | 21 ± 0.22 d | 23 ± 0.17 d | - | 14 ± 0.14 d | 17 ± 0.32 d | 19 ± 0.21 d | 21 ± 0.14 d | - | 11 ± 0.47 d | 15 ± 0.45 c | 20 ± 0.33 cd | 23 ± 0.12 d |
| Microorganisms | BKH | RKH | WKH | ||||||||||||
|---|---|---|---|---|---|---|---|---|---|---|---|---|---|---|---|
| 50 | 100 | 200 | 400 | 800 | 50 | 100 | 200 | 400 | 800 | 50 | 100 | 200 | 400 | 800 | |
| Fungi | |||||||||||||||
| A. niger | 9 ± 0.0 d | 13 ± 0.2 d | 14 ± 0.2 d | 18 ± 0.1 e | 23 ± 0.2 e | - | 10 ± 0.1 d | 12 ± 0.3 d | 16 ± 0.2 d | 21 ± 0.2 f | - | - | 10 ± 0.1 d | 13 ± 0.2 d | 18 ± 0.2 f |
| A. fumigatus | 11 ± 0.1 c | 15 ± 0.4 c | 16 ± 0.1 bc | 21 ± 0.3 d | 27 ± 0.1 d | - | 12 ± 0.2 c | 14 ± 1 c | 19 ± 0.3 c | 25 ± 0.4 d | - | - | 12 ± 0.2 bc | 16 ± 0.1 c | 22 ± 0.1 d |
| A. flavus | 10 ± 0.2 c | 14 ± 0.3 c | 15 ± 0.4 c | 20 ± 0.1 de | 24 ± 0.8 e | - | 13 ± 0.6 bc | 14 ± 0.4 c | 18 ± 0.8 cd | 22 ± 0.7 e | - | - | 11 ± 0.4 c | 15 ± 0.5 cd | 19 ± 0.4 e |
| P. chrysogenum | 12 ± 0.4 b | 16 ± 0.5 b | 17 ± 0.8 b | 23 ± 0.4 c | 29 ± 0.7 c | - | 14 ± 0.4 b | 15 ± 0.5 b | 21 ± 0.7 bc | 27 ± 0.3 c | - | - | 13 ± 0.5 b | 18 ± 0.1 bc | 24 ± 0.5 c |
| F. equiseti | 15 ± 0.7 a | 19 ± 0.7 a | 20 ± 0.7 a | 26 ± 0.5 a | 33 ± 0.9 a | - | 17 ± 0.3 a | 18 ± 0.7 a | 24 ± 0.9 a | 31 ± 0.5 a | - | - | 16 ± 0.7 a | 21 ± 0.2 a | 28 ± 0.8 a |
| F. avenaceum | 14 ± 0.6 ab | 18 ± 0.1 ab | 19 ± 0.3 ab | 24 ± 0.3 b | 31 ± 0.5 b | - | 16 ± 0.1 ab | 17 ± 0.6 ab | 22 ± 0.1 b | 29 ± 0.4 b | - | - | 15 ± 0.1 ab | 19 ± 0.4 b | 26 ± 0.4 b |
| Candida | |||||||||||||||
| C. gelbeta | 9 ± 0.1 d | 12 ± 0.4 d | 15 ± 0.2 e | 18 ± 0.5 e | 25 ± 0.1 e | - | 10 ± 0.5 c | 12 ± 0.1 e | 16 ± 0.5 d | 22 ± 0.4 e | - | 8 ± 0.1 d | 10 ± 0.1 e | 14 ± 0.8 d | 18 ± 0.1 e |
| C. tropicalis | 11 ± 0.3 c | 15 ± 0.2 bc | 19 ± 0.0 c | 22 ± 0.1 cd | 30 ± 0.2 c | - | 12 ± 0.1 bc | 15 ± 0.2 c | 20 ± 0.1 bc | 27 ± 0.7 c | - | 10 ± 0.4 bc | 13 ± 0.4 cd | 18 ± 0.7 bc | 23 ± 0.5 c |
| C. albicans | 10 ± 0.1 cd | 13 ± 0.9 c | 17 ± 0.3 d | 21 ± 0.2 d | 28 ± 0.8 d | - | 11 ± 0.2 c | 14 ± 0.7 d | 19 ± 0.2 c | 25 ± 0.4 d | - | 9 ± 0.1 c | 12 ± 0.5 d | 17 ± 0.6 c | 21 ± 0.3 d |
| R. rubra | 14 ± 0.6 ab | 17 ± 0.7 ab | 21 ± 0.4 b | 25 ± 0.4 b | 32 ± 0.7 b | 13 ± 0.1 ab | 15 ± 0.7 ab | 18 ± 0.9 b | 22 ± 0.4 ab | 29 ± 0.2 b | - | 13 ± 0.5 ab | 16 ± 0.2 b | 20 ± 0.1 ab | 25 ± 0.6 b |
| R. minuta | 13 ± 0.4 b | 16 ± 0.6 b | 20 ± 0.1 bc | 23 ± 0.9 c | 31 ± 0.1 bc | 12 ± 0.5 b | 13 ± 0.6 b | 16 ± 0.6 c | 21 ± 0.4 b | 28 ± 0.5 bc | - | 11 ± 0.1 b | 14 ± 0.7 c | 19 ± 0.2 b | 24 ± 0.4 bc |
| R.mucilginosa | 15 ± 0.9 a | 18 ± 0.5 a | 23 ± 0.9 a | 27 ± 0.0 a | 34 ± 0.2 a | 14 ± 0.4 a | 16 ± 0.9 a | 20 ± 0.4 a | 23 ± 0.1 a | 31 ± 0.1 a | - | 14 ± 0.4 a | 18 ± 0.2 a | 21 ± 0.7 a | 27 ± 0.7 a |
| Microorganisms | BKH | RKH | WKH | |||
|---|---|---|---|---|---|---|
| Bacteria | MIC | MBC | MIC | MBC | MIC | MBC |
| Bacillus cereus | 30 e | 55 e | 40 e | 80 e | 65 e | 120 e |
| listeria monocytogenes | 35 d | 65 d | 45 d | 85 d | 70 d | 130 d |
| Streptococcus pyogenes | 25 f | 50 f | 35 f | 65 f | 60 f | 110 f |
| Escherichia coli | 40 c | 75 c | 65 c | 125 c | 75 c | 140 c |
| Campylobacter jejuni | 45 a | 85 a | 75 a | 145 a | 90 a | 175 a |
| Salmonella typhi | 40 b | 75 b | 70 b | 130 b | 80 b | 155 b |
| Fungi | MIC | MFC | MIC | MFC | MIC | MFC |
| Aspergillus niger | 45 a | 90 a | 90 a | 170 a | 180 a | 320 a |
| Aspergillus fumigatus | 35 c | 70 c | 75 c | 140 c | 140 c | 270 c |
| Aspergillus flavus | 40 b | 75 b | 80 b | 150 b | 150 b | 280 b |
| Penicillium chrysogenum | 30 d | 55 d | 70 d | 130 d | 135 d | 250 d |
| Fusarium equiseti | 25 f | 50 f | 60 f | 110 f | 110 f | 200 f |
| Fusarium avenaceum | 30 e | 55 e | 65 e | 120 e | 120 e | 220 e |
| Candida | ||||||
| Candia gelbeta | 45 a | 90 a | 80 a | 150 a | 90 a | 170 a |
| Candida tropicalis | 35 c | 70 c | 65 c | 120 c | 80 c | 150 c |
| Candida albicans | 40 b | 75 b | 70 b | 130 b | 85 b | 160 b |
| Rhodotorula rubra | 25 e | 50 e | 40 e | 70 e | 65 e | 120 e |
| Rhodotorula minuta | 30 d | 55 d | 45 d | 80 d | 70 d | 130 d |
| Rhodotorula mucilginosa | 20f | 40f | 30 f | 60 f | 55 f | 100 f |
| Sample | Concn (µg/g) | Duration of Cold Storage (Days) | |||||||||||||||
|---|---|---|---|---|---|---|---|---|---|---|---|---|---|---|---|---|---|
| 0 | 10 | 20 | 30 | 0 | 10 | 20 | 30 | 0 | 10 | 20 | 30 | 0 | 10 | 20 | 30 | ||
| pH | TVBN (mg N/100 g Sample) | Metmyoglobin (%) | Lipid Oxidation Inhibition (%) | ||||||||||||||
| Cont | 0.0 | 5.60 a | 6.57 a | 7.50 a | 8.90 a | 6.50 a | 7.20 a | 7.80 a | 8.35 a | 9.00 a | 28.00 a | 42.00 a | 52.50 a | 33 ab | 24 c | 18 c | 9 d |
| BKH | 200 | 5.45 b | 5.90 c | 6.45 c | 7.00 c | 6.22 c | 6.50 c | 6.95 c | 7.20 c | 8.99 a | 18.00 c | 21.00 b | 30.00 b | 33 ab | 29 b | 27 c | 17 c |
| 400 | 5.31 b | 5.70 c | 6.20 c | 6.82 d | 6.10 d | 6.20 c | 6.45 c | 6.80 d | 8.15 b | 13.90 d | 16.00 c | 25.00 c | 33 ab | 31 b | 29 b | 25 b | |
| 800 | 5.19 c | 5.66 c | 5.90 d | 6.24 d | 5.56 e | 5.86 d | 6.30 c | 6.50 d | 7.51 c | 11.30 d | 14.55 c | 22.60 c | 34 a | 33 a | 32 a | 30 a | |
| RKH | 200 | 5.48 b | 6.00 b | 7.00 b | 7.41 b | 6.34 b | 6.80 b | 7.20 b | 7.40 c | 8.8 a | 20.30 b | 25.90 b | 35.00 b | 33 ab | 27 c | 25 c | 14 c |
| 400 | 5.34 b | 5.70 c | 6.50 c | 6.90 d | 6.19 c | 6.40 c | 6.90 c | 7.15 c | 8.3 b | 16.10 c | 23.10 b | 31.50 b | 34 a | 30 b | 28 b | 21 c | |
| 800 | 5.29 c | 5.50 c | 6.20 c | 6.50 d | 6.11 d | 6.31 c | 6.50 c | 6.80 d | 7.9 c | 13.30 d | 16.80 c | 27.30 c | 35 a | 32 ab | 30 b | 28 b | |
| WKH | 200 | 5.56 ab | 6.20 b | 7.10 b | 7.65 b | 6.40 ab | 7.00 ab | 7.40 b | 7.90 b | 8.90 a | 22.40 b | 28.00 b | 37.80 b | 35 a | 25 c | 23 c | 11 d |
| 400 | 5.45 b | 6.00 b | 6.80 c | 7.10 c | 6.35 b | 6.70 b | 7.00 b | 7.20 c | 8.5 ab | 17.50 c | 24.50 b | 31.50 b | 34 a | 27 c | 25 c | 19 c | |
| 800 | 5.33 b | 5.80 c | 6.20 c | 6.78 d | 6.21 c | 6.45 b | 6.80 c | 7.00 c | 8.2 b | 14.70 d | 20.30 c | 28.00 c | 35 a | 29 b | 28 b | 22 c | |
| Sample | Concn (µg/g) | Storage (Day) | |||||||||
|---|---|---|---|---|---|---|---|---|---|---|---|
| 0 | 30 | 0 | 30 | 0 | 30 | 0 | 30 | 0 | 30 | ||
| Tenderness | Juiciness | Taste | Aroma | Overall Acceptability | |||||||
| Cont. | 0 | 7.9 ± 0.1 a | 4.2 ± 0.2 b | 8.4 ± 0.2 a | 3.3 ± 0.2 b | 8.5 ± 0.1 a | 3.0 ± 0.2 b | 7.4 ± 0.6 a | 2.6 ± 0.5 b | 8.0 ± 0.1 a | 3.3 ± 0.2 b |
| BKH | 200 | 8.6 ± 0.3 a | 5.0 ± 0.3 b | 8.4 ± 0.4 a | 4.3 ± 0.6 b | 8.5 ± 0.1 a | 3.5 ± 0.4 b | 7.7 ± 0.7 a | 3.3 ± 0.3 b | 8.3 ± 0.2 a | 4.0 ± 0.7 b |
| 400 | 8.1 ± 0.2 a | 5.1 ± 0.4 b | 8.6 ± 0.3 a | 4.7 ± 0.7 b | 8.7 ± 0.3 a | 3.7 ± 0.8 b | 7.4 ± 0.2 a | 3.7 ± 0.6 b | 8.2 ± 0.1 a | 4.3 ± 0.1 b | |
| 800 | 8.5 ± 0.4 a | 5.3 ± 0.5 b | 8.7 ± 0.3 a | 4.9 ± 0.8 b | 8.7 ± 0.3 a | 3.9 ± 0.6 b | 7.5 ± 0.5 a | 3.7 ± 0.5 b | 8.4 ± 0.6 a | 4.5 ± 0.3 b | |
| RKH | 200 | 8.1 ± 0.5 a | 4.3 ± 0.3 b | 8.6 ± 0.2 a | 4.4 ± 0.4 b | 8.5 ± 0.2 a | 3.3 ± 0.3 b | 7.2 ± 0.3 a | 2.7 ± 0.5 b | 8.1 ± 0.6 a | 3.7 ± 0.5 b |
| 400 | 8.3 ± 0.2 a | 4.6 ± 0.1 b | 8.5 ± 0.2 a | 4.3 ± 0.3 b | 8.6 ± 0.3 a | 3.4 ± 0.1 b | 7.5 ± 0.4 a | 2.9 ± 0.4 b | 8.2 ± 0.7 a | 3.8 ± 0.9 b | |
| 800 | 8.4 ± 0.2 a | 4.7 ± 0.2 b | 8.5 ± 0.3 a | 4.1 ± 0.5 b | 8.7 ± 0.2 a | 3.4 ± 0.3 b | 7.9 ± 0.6 a | 3.0 ± 0.2 b | 8.4 ± 0.2 a | 3.8 ± 0.3 b | |
| WKH | 200 | 8.0 ± 0.2 a | 4.6 ± 0.3 b | 8.5 ± 0.3 a | 3.4 ± 0.5 b | 8.6 ± 0.2 a | 3.1 ± 0.1 b | 7.0 ± 0.5 a | 2.9 ± 0.2 b | 8.0 ± 0.1 a | 3.5 ± 0.6 b |
| 400 | 8.2 ± 0.3 a | 4.9 ± 0.1 b | 8.5 ± 0.2 a | 3.7 ± 0.4 b | 8.5 ± 0.1 a | 3.2 ± 0.2 b | 7.4 ± 0.7 a | 3.0 ± 0.4 b | 8.2 ± 0.2 a | 3.7 ± 0.4 b | |
| 800 | 8.2 ± 0.1 a | 4.7 ± 0.2 b | 8.6 ± 0.1 a | 3.9 ± 0.2 b | 8.6 ± 0.1 a | 3.3 ± 0.1 b | 7.6 ± 0.6 a | 3.2 ± 0.3 b | 8.2 ± 0.4 a | 3.7 ± 0.8 b | |
| Sample | Concn (µg/g) | Storage (Day) | |||||||
|---|---|---|---|---|---|---|---|---|---|
| 0 | 10 | 20 | 30 | 0 | 10 | 20 | 30 | ||
| Total Bacterial Count (Log CFU/g) | Psychrophilic Bacterial Count (Log CFU/g) | ||||||||
| BKH | 0 | 3.50 ± 0.17 a | 5.10 ± 0.19 a | 7.9 ± 0.22 a | 10.2 ± 0.14 a | 2.80 ± 0.17 a | 4.50 ± 0.23 ab | 7.50 ± 0.18 a | 9.20 ± 0.12 a |
| 200 | 3.31 ± 0.15 b | 4.30 ± 0.21 b | 6.0 ± 0.24 c | 8.8 ± 0.17 b | 2.66 ± 0.19 b | 3.90 ± 0.25 c | 6.20 ± 0.19 b | 8.50 ± 0.19 ab | |
| 400 | 3.25 ± 0.15 b | 4.00 ± 0.12 b | 5.7 ± 0.21 d | 7.7 ± 0.14 c | 2.41 ± 0.22 c | 3.50 ± 0.31 c | 5.90 ± 0.21 c | 7.40 ± 0.15 b | |
| 800 | 3.18 ± 0.11 b | 3.80 ± 0.15 c | 5.0 ± 0.28 d | 6.2 ± 0.22 d | 2.33 ± 0.31 c | 3.10 ± 0.33 c | 4.90 ± 0.39 d | 6.00 ± 0.17 c | |
| RKH | 0 | 3.60 ± 0.21 a | 5.30 ± 0.18 a | 8.2 ± 0.31 a | 9.8 ± 0.21 a | 2.75 ± 0.18 a | 4.30 ± 0.25 b | 6.90 ± 0.22 ab | 8.40 ± 0.32 a |
| 200 | 3.33 ± 0.14 b | 4.60 ± 0.13 b | 7.1 ± 0.25 b | 8.1 ± 0.23 b | 2.61 ± 0.21 b | 4.00 ± 0.27 b | 6.10 ± 0.31 b | 7.90 ± 0.35 b | |
| 400 | 3.29 ± 0.15 b | 4.40 ± 0.14 b | 6.3 ± 0.21 c | 7.5 ± 0.33 c | 2.55 ± 0.16 b | 3.80 ± 0.31 c | 5.80 ± 0.18 c | 7.10 ± 0.18 b | |
| 800 | 3.21 ± 0.13 b | 4.10 ± 0.18 b | 5.8 ± 0.28 d | 7.0 ± 0.11 c | 2.45 ± 0.18 c | 3.50 ± 0.21 c | 5.30 ± 0.23 c | 6.50 ± 0.22 c | |
| WKH | 0 | 3.50 ± 0.15 a | 5.20 ± 0.14 a | 8.4 ± 0.21 a | 10.0 ± 0.11 a | 2.80 ± 0.12 a | 4.70 ± 0.22 a | 7.10 ± 0.12 a | 8.90 ± 0.21 ab |
| 200 | 3.40 ± 0.18 b | 4.90 ± 0.12 ab | 7.3 ± 0.25 b | 8.5 ± 0.12 b | 2.79 ± 0.15 a | 4.40 ± 0.24 ab | 6.80 ± 0.15 ab | 7.40 ± 0.32 b | |
| 400 | 3.30 ± 0.17 b | 4.70 ± 0.15 b | 6.8 ± 0.27 c | 7.4 ± 0.15 c | 2.62 ± 0.14 b | 4.20 ± 0.27 b | 6.10 ± 0.19 b | 7.00 ± 0.28 b | |
| 800 | 3.20 ± 0.16 b | 4.50 ± 0.14 b | 6.5 ± 0.23 c | 7.0 ± 0.19 c | 2.59 ± 0.16 b | 4.00 ± 0.23 b | 5.80 ± 0.21 c | 6.70 ± 0.22 c | |
Publisher’s Note: MDPI stays neutral with regard to jurisdictional claims in published maps and institutional affiliations. |
© 2021 by the authors. Licensee MDPI, Basel, Switzerland. This article is an open access article distributed under the terms and conditions of the Creative Commons Attribution (CC BY) license (https://creativecommons.org/licenses/by/4.0/).
Share and Cite
Saad, A.M.; Sitohy, M.Z.; Ahmed, A.I.; Rabie, N.A.; Amin, S.A.; Aboelenin, S.M.; Soliman, M.M.; El-Saadony, M.T. Biochemical and Functional Characterization of Kidney Bean Protein Alcalase-Hydrolysates and Their Preservative Action on Stored Chicken Meat. Molecules 2021, 26, 4690. https://doi.org/10.3390/molecules26154690
Saad AM, Sitohy MZ, Ahmed AI, Rabie NA, Amin SA, Aboelenin SM, Soliman MM, El-Saadony MT. Biochemical and Functional Characterization of Kidney Bean Protein Alcalase-Hydrolysates and Their Preservative Action on Stored Chicken Meat. Molecules. 2021; 26(15):4690. https://doi.org/10.3390/molecules26154690
Chicago/Turabian StyleSaad, Ahmed M., Mahmoud Z. Sitohy, Alshaymaa I. Ahmed, Nourhan A. Rabie, Shimaa A. Amin, Salama M. Aboelenin, Mohamed M. Soliman, and Mohamed T. El-Saadony. 2021. "Biochemical and Functional Characterization of Kidney Bean Protein Alcalase-Hydrolysates and Their Preservative Action on Stored Chicken Meat" Molecules 26, no. 15: 4690. https://doi.org/10.3390/molecules26154690
APA StyleSaad, A. M., Sitohy, M. Z., Ahmed, A. I., Rabie, N. A., Amin, S. A., Aboelenin, S. M., Soliman, M. M., & El-Saadony, M. T. (2021). Biochemical and Functional Characterization of Kidney Bean Protein Alcalase-Hydrolysates and Their Preservative Action on Stored Chicken Meat. Molecules, 26(15), 4690. https://doi.org/10.3390/molecules26154690

